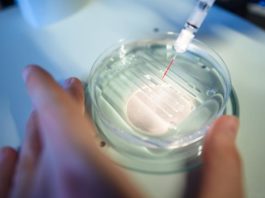

Turtle Beach готовит геймерские наушники Stealth 600 и Stealth 700
Беспроводные наушники специализированного типа и назначения – например, для виртуальных сражений – так или иначе должны...
ZTE Axon M — смартфон с двойным дисплеем необычной конструкции
Новое поколение особенных смартфонов с двумя дисплеями уже не за горами – первые такие инженерные образцы были анонсиро...
Nokia собирается покорить рынок Smart TV
Такую техническую компанию как Nokia по праву можно считать культовой. В своё время она являлась чуть ли не лидером на р...
Канал JerryRigEverything раскрыл некоторые подробности о сканере отпечатка пальцев в Galaxy S21 Ultra
По мере того, как заинтересованная общественность и эксперты в области мобильной индустрии продолжают изучать и рассмат...
Бумажные напульсники, предупреждающие об ультрафиолете
В то время как для организма полезно получать витамин D в достаточных количествах при помощи солнечного света, стоит по...
Теперь мы знаем о Galaxy S20 Fan Edition всё
Последние два месяца по сети крайне активно ходили слухи касательно очередного смартфона от южнокорейского производителя...
В сеть утекли сведения о технических характеристиках смартфона OnePlus 6
Компания OnePlus продолжает радовать и одновременно удивлять своих поклонников и всех ценителей современных мобильных н...
Как выжить во время схода лавины
Для того чтобы увеличить шансы экстремалов на выживание во время схода лавины компания North Face представила свое новое...
Amazon утвердила запуск революционных KuiperSat-1 и KuiperSat-2
Торгово-техническая корпорация Amazon сумела достичь ещё одной крайне важной вехи на пути к достижению своей, весьма амб...
Dell анонсировала XPS 15 в «морозном» цвете
Несмотря на тот факт, что сейчас компания Dell многие уже не воспринимают всерьёз, она всё же до сих пор является крайне...